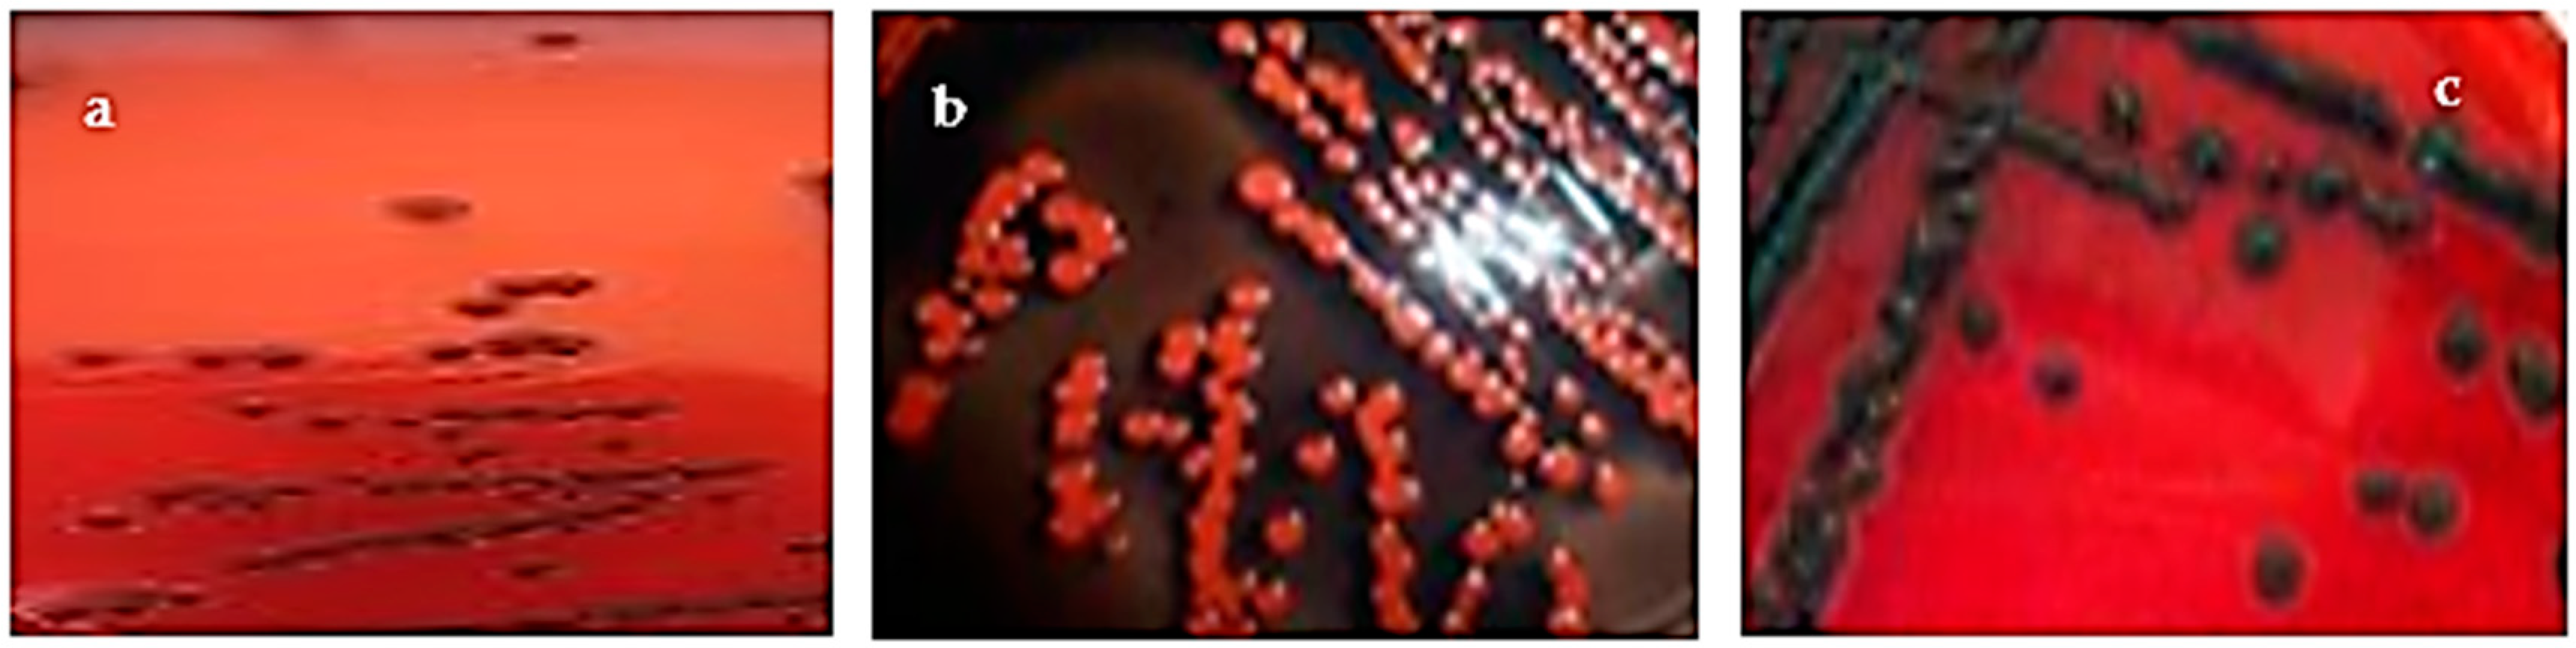
Microorganisms 11 01353 g001

Antibiotics Resistance and Adhesive Properties of Clinical Staphylococcus aureus Isolated from Wound Infections
Abstract
1. Introduction
2. Materials and Methods
2.1. Tested Strains and Culture Conditions
2.2. Study of Exopolysaccharide Production
2.3. Quantitative Biofilm Production Assay by S. aureus Cells
2.4. Detection of ica A and ica D loci, cna, fnbA, fnbB and clfA Adhesins Genes
2.5. PCR Amplification of Efflux Pump Genes
2.6. Detection of mec A, blaZ, norA and norB Genes
2.7. Study of Antimicrobial Susceptibility Profile
3. Results
3.1. Qualitative and Quantitative Study of Biofilm Formation
3.2. Distribution of Adhesion Genes
3.3. Distribution of Antibiotic Resistance Genes
4. Discussion
5. Conclusions
Supplementary Materials
Author Contributions
Funding
Data Availability Statement
Acknowledgments
Conflicts of Interest
References
- Rezia, R.A.; Vijendra, R.; Gopi, A. Uropathogens causing urinary tract infection in adults in a tertiary care hospital. J. Pharmacol. Pharmacother. 2020, 11, 119–124. [Google Scholar]
- Savini, V. Pet-to-Man Travelling Staphylococci: A World in Progress; Academic Press: New York, NY, USA, 2018. [Google Scholar]
- Hindy, J.R.; Quintero-Martinez, J.A.; Lee, A.T.; Scott, C.G.; Gerberi, D.J.; Mahmood, M.; DeSimone, D.C.; Baddour, L.M. Incidence Trends and Epidemiology of Staphylococcus aureus Bacteremia: A Systematic Review of Population-Based Studies. Cureus 2022, 29, e25460. [Google Scholar] [CrossRef] [PubMed]
- Laupland, K.B.; Steele, L.; Pasquill, K.; Parfitt, E.C. Staphylococcus aureus bloodstream infection: Secular changes associated with the implementation of a de novo clinical infectious diseases service in a Canadian population. Int. J. Infect. Dis. 2021, 104, 45–49. [Google Scholar] [CrossRef] [PubMed]
- Sakwinska, O.; Giddey, M.; Moreillon, M.; Morisset, D.; Waldvogel, A.; Moreillon, P. Staphylococcus aureus host range and human-bovine host shift. Appl. Environ. Microbiol. 2011, 77, 5908–5915. [Google Scholar] [CrossRef]
- Vos, P.; Garrity, G.; Jones, D.; Krieg, N.R.; Ludwig, W.; Rainey, F.A.; Schleifer, K.-H.; Whitman, W.B. Bergey’s Manual of Systematic Bacteriology: Volume 3: The Firmicutes; Springer Science & Business Media: Berlin/Heidelberg, Germany, 2011; Volume 3. [Google Scholar]
- Gong, C.; Guan, W.; Liu, X.; Zheng, Y.; Li, Z.; Zhang, Y.; Zhu, S.; Jiang, H.; Cui, Z.; Wu, S. Biomimetic Bacteriophage-Like Particles Formed from Probiotic Extracts and NO Donors for Eradicating Multidrug-Resistant Staphylococcus aureus. Adv. Mater. 2022, 34, e2206134. [Google Scholar] [CrossRef]
- Morar, A.; Ban-Cucerzan, A.; Herman, V.; Tîrziu, E.; Sallam, K.I.; Abd-Elghany, S.M.; Imre, K. Multidrug resistant coagulase-positive Staphylococcus aureus and their enterotoxins detection in traditional cheeses marketed in Banat Region, Romania. Antibiotics 2021, 10, 1458. [Google Scholar] [CrossRef]
- Onyango, L.A.; Alreshidi, M.M. Adaptive metabolism in staphylococci: Survival and persistence in environmental and clinical settings. J. Pathog. 2018, 2018, 1092632. [Google Scholar] [CrossRef]
- Yarovoy, J.Y.; Monte, A.A.; Knepper, B.C.; Young, H.L. Epidemiology of Community-Onset Staphylococcus aureus Bacteremia. West J. Emerg. Med. 2019, 20, 438–442. [Google Scholar] [CrossRef]
- Vuong, C.; Kocianova, S.; Voyich, J.M.; Yao, Y.; Fischer, E.R.; DeLeo, F.R.; Otto, M. A crucial role for exopolysaccharide modification in bacterial biofilm formation, immune evasion, and virulence. J. Biol. Chem. 2004, 279, 54881–54886. [Google Scholar] [CrossRef]
- Foster, T.J.; Geoghegan, J.A.; Ganesh, V.K.; Höök, M. Adhesion, invasion and evasion: The many functions of the surface proteins of Staphylococcus aureus. Nat. Rev. Microbiol. 2014, 12, 49–62. [Google Scholar] [CrossRef]
- Blaiotta, G.; Pennacchia, C.; Villani, F.; Ricciardi, A.; Tofalo, R.; Parente, E. Diversity and dynamics of communities of coagulase-negative staphylococci in traditional fermented sausages. J. Appl. Microbiol. 2004, 97, 271–284. [Google Scholar] [CrossRef] [PubMed]
- Donlan, R.M.; Costerton, J.W. Biofilms: Survival mechanisms of clinically relevant microorganisms. Clin. Microbiol. Rev. 2002, 15, 167–193. [Google Scholar] [CrossRef] [PubMed]
- Kot, B.; Sytykiewicz, H.; Sprawka, I. Expression of the biofilm-associated genes in methicillin-resistant Staphylococcus aureus in biofilm and planktonic conditions. Int. J. Mol. Sci. 2018, 19, 3487. [Google Scholar] [CrossRef] [PubMed]
- Foster, T.J. Surface Proteins of Staphylococcus aureus. Microbiol. Spectr. 2019, 7, 4. [Google Scholar] [CrossRef]
- Murai, M.; Moriyama, H.; Hata, E.; Takeuchi, F.; Amemura-Maekawa, J. Variation and association of fibronectin-binding protein genes fnbA and fnbB in Staphylococcus aureus Japanese isolates. Microbiol. Immunol. 2016, 60, 312–325. [Google Scholar] [CrossRef]
- Snoussi, M.; Noumi, E.; Cheriaa, J.; Usai, D.; Sechi, L.A.; Zanetti, S.; Bakhrouf, A. Adhesive properties of environmental Vibrio alginolyticus strains to biotic and abiotic surfaces. New Microbiol. 2008, 31, 489–500. [Google Scholar] [PubMed]
- Freeman, D.; Falkiner, F.; Keane, C. New method for detecting slime production by coagulase negative staphylococci. J. Clin. Pathol. 1989, 42, 872–874. [Google Scholar] [CrossRef] [PubMed]
- Arciola, C.R.; Campoccia, D.; Gamberini, S.; Cervellati, M.; Donati, E.; Montanaro, L. Detection of slime production by means of an optimised Congo red agar plate test based on a colourimetric scale in Staphylococcus epidermidis clinical isolates genotyped for ica locus. Biomaterials 2002, 23, 4233–4239. [Google Scholar] [CrossRef]
- Ziebuhr, W.; Krimmer, V.; Rachid, S.; Lößner, I.; Götz, F.; Hacker, J. A novel mechanism of phase variation of virulence in Staphylococcus epidermidis: Evidence for control of the polysaccharide intercellular adhesin synthesis by alternating insertion and excision of the insertion sequence element IS256. Mol. Microbiol. 1999, 32, 345–356. [Google Scholar] [CrossRef]
- Knobloch, J.K.-M.; Bartscht, K.; Sabottke, A.; Rohde, H.; Feucht, H.-H.; Mack, D. Biofilm formation by Staphylococcus epidermidis depends on functional RsbU, an activator of the sigB operon: Differential activation mechanisms due to ethanol and salt stress. J. Bacteriol. 2001, 183, 2624–2633. [Google Scholar] [CrossRef]
- Christensen, G.D.; Simpson, W.; Younger, J.; Baddour, L.; Barrett, F.; Melton, D.; Beachey, E. Adherence of coagulase-negative staphylococci to plastic tissue culture plates: A quantitative model for the adherence of staphylococci to medical devices. J. Clin. Microbiol. 1985, 22, 996–1006. [Google Scholar] [CrossRef]
- Chaieb, K.; Chehab, O.; Zmantar, T.; Rouabhia, M.; Mahdouani, K.; Bakhrouf, A. In vitro effect of pH and ethanol on biofilm formation by clinical ica-positive Staphylococcus epidermidis strains. Ann. Microbiol. 2007, 57, 431–437. [Google Scholar] [CrossRef]
- Rohde, H.; Knobloch, J.K.; Horstkotte, M.A.; Mack, D. Correlation of Staphylococcus aureus icaADBC genotype and biofilm expression phenotype. J. Clin. Microbiol. 2001, 39, 4595–4596. [Google Scholar] [CrossRef] [PubMed]
- Arciola, C.R.; Campoccia, D.; Gamberini, S.; Baldassarri, L.; Montanaro, L. Prevalence of cna fnbA and fnbB adhesin genes among Staphylococcus aureus isolates from orthopedic infections associated to different types of implant. FEMS Microbiol. Lett. 2005, 246, 81–86. [Google Scholar] [CrossRef] [PubMed]
- McDevitt, D.; Francois, P.; Vaudaux, P.; Foster, T. Identification of the ligand-binding domain of the surface-located fibrinogen receptor (clumping factor) of Staphylococcus aureus. Mol. Microbiol. 1995, 16, 895–907. [Google Scholar] [CrossRef] [PubMed]
- Geha, D.J.; Uhl, J.R.; Gustaferro, C.A.; Persing, D.H. Multiplex PCR for identification of methicillin-resistant staphylococci in the clinical laboratory. J. Clin. Microbiol. 1994, 32, 1768–1772. [Google Scholar] [CrossRef] [PubMed]
- Martineau, F.; Picard, F.J.; Lansac, N.; Ménard, C.; Roy, P.H.; Ouellette, M.; Bergeron, M.G. Correlation between the resistance genotype determined by multiplex PCR assays and the antibiotic susceptibility patterns of Staphylococcus aureus and Staphylococcus epidermidis. Antimicrob. Agents Chemother. 2000, 44, 231–238. [Google Scholar] [CrossRef]
- Bazaid, A.S.; Saeed, A.; Alrashidi, A.; Alrashidi, A.; Alshaghdali, K.; Hammam, A.S.; Alreshidi, T.; Alshammary, M.; Alarfaj, A.; Thallab, R. Antimicrobial surveillance for bacterial uropathogens in Ha’il, Saudi Arabia: A Five-year multicenter retrospective study. Infect. Drug Resist. 2021, 14, 1455–1465. [Google Scholar] [CrossRef]
- Otarigho, B.; Falade, M.O. Analysis of antibiotics resistant genes in different strains of Staphylococcus aureus. Bioinformation 2018, 14, 113. [Google Scholar] [CrossRef]
- Otto, M. MRSA virulence and spread. Cell. Microbiol. 2012, 14, 1513–1521. [Google Scholar] [CrossRef]
- Cue, D.; Lei, M.G.; Lee, C.Y. Genetic regulation of the intercellular adhesion locus in staphylococci. Front. Cell. Infect. Microbiol. 2012, 2, 38. [Google Scholar] [CrossRef]
- Montanaro, L.; Arciola, C.; Borsetti, E.; Collamati, S.; Baldassarri, L. Detection of fibronectin-binding protein genes in staphylococcal strains from peri-prosthesis infections. New Microbiol. 1999, 22, 331–336. [Google Scholar]
- He, L.; Zhang, F.; Jian, Y.; Lv, H.; Hamushan, M.; Liu, J.; Liu, Y.; Wang, H.; Tang, J.; Han, P.; et al. Key role of quorum-sensing mutations in the development of Staphylococcus aureus clinical device-associated infection. Clin. Transl. Med. 2022, 12, e801. [Google Scholar] [CrossRef] [PubMed]
- Said-Salim, B.; Dunman, P.; McAleese, F.; Macapagal, D.; Murphy, E.; McNamara, P.; Arvidson, S.; Foster, T.; Projan, S.; Kreiswirth, B. Global regulation of Staphylococcus aureus genes by Rot. J. Bacteriol. 2003, 185, 610–619. [Google Scholar] [CrossRef] [PubMed]
- Mathur, T.; Singhal, S.; Khan, S.; Upadhyay, D.; Fatma, T.; Rattan, A. Detection of biofilm formation among the clinical isolates of staphylococci: An evaluation of three different screening methods. Indian J. Med. Microbiol. 2006, 24, 25–29. [Google Scholar] [CrossRef] [PubMed]
- Piechota, M.; Kot, B.; Frankowska-Maciejewska, A.; Grużewska, A.; Woźniak-Kosek, A. Biofilm formation by methicillin-resistant and methicillin-sensitive Staphylococcus aureus strains from hospitalized patients in Poland. BioMed Res. Int. 2018, 2018, 4657396. [Google Scholar] [CrossRef]
- Foster, T.J. The MSCRAMM family of cell-wall-a.nchored surface proteins of gram-positive cocci. Trends Microbiol. 2019, 27, 927–941. [Google Scholar] [CrossRef]

| Gene | Primer Sequence 5′-3′ | Amplicon Size (bp) | References |
|---|---|---|---|
| icaA | ACACTTGCTGGCGCAGTCAA TCTGGAACCAACATCCAACA | 188 | [27] |
| icaD | ATGGTCAAGCCCAGACAGAG AGTATTTTCAATGTTTAAAGCAA | 198 | [27] |
| cna | AAAGCGTTGCCTAGTGGAGA AGTGCCTTCCCAAACCTTTT | 192 | [28] |
| fnbA | GATACAAACCCAGGTGGTGG TGTGCTTGACCATGCTCTTC | 191 | [28] |
| fnbB | TGTGCTTGACCATGCTCTTC AGTTGATGTCGCGCTGTATG | 201 | [28] |
| clfA | CCGGATCCGTAGCTGCAGATGCACC GCTCTAGATCACTCATCAGGTTGTTCAGG | 1000 | [29] |
| Gene | Primer Sequence 5′-3′ | Amplicon Size (bp) | References |
|---|---|---|---|
| mecA | AACAGGTGAATTATTAGCACTTGTAAG ATTGCTGTTAATATTTTTTGAGTTGA | 140 | [30] |
| norA | TTCACCAAGCCATCAAAAAG CTTGCCTTTCTCCAGCAATA | 620 | [31] |
| norB | AGCGCGTTGTCTATCTTTCC GCAGGTGGTCTTGCTGATAA | 213 | [31] |
| blaZ | ACTTCAACACCTGCTGCTTTC TGACCACTTTTATCAGCAACC | 172 | [32] |
| Strains | OD570 ± SD | Biofilm Production | Phenotype on CRA | Slime | ica A/icaD Gene |
|---|---|---|---|---|---|
| S. aureus ATCC 43300 | 1.89 ± 0.13 | High biofilm | Very Black | S+ | icaA+/icaD + |
| S1 | 0.11 ± 0.01 | Moderate biofilm | Bordeaux | S− | icaA+/icaD + |
| S2 | 0.11 ± 0.01 | Moderate biofilm | Almost black | S− | icaA+/icaD + |
| S3 | 0.45 ± 0.01 | Moderate biofilm | Bordeaux | S− | icaA+/icaD + |
| S4 | 0.48 ± 0.04 | Moderate biofilm | Almost black | S− | icaA+/icaD + |
| S5 | 0.52 ± 0.01 | Moderate biofilm | Bordeaux | S− | icaA+/icaD + |
| S6 | 0.35 ± 0.03 | Moderate biofilm | Almost black | S− | icaA+/icaD + |
| S7 | 0.57 ± 0.04 | Moderate biofilm | Bordeaux | S− | icaA+/icaD + |
| S8 | 0.79 ± 0.01 | Moderate biofilm | Almost black | S− | icaA+/icaD + |
| S9 | 0.51 ± 0.01 | Moderate biofilm | Bordeaux | S− | icaA+/icaD + |
| S10 | 0.77 ± 0.02 | Moderate biofilm | Almost black | S− | icaA+/icaD + |
| S11 | 0.12 ± 0.01 | Moderate biofilm | Bordeaux | S− | icaA −/icaD − |
| S12 | 0.13 ± 0.01 | Moderate biofilm | Bordeaux | S− | icaA −/icaD − |
| S13 | 0.34 ± 0.01 | Moderate biofilm | Bordeaux | S− | icaA+/icaD + |
| S14 | 0.12 ± 0.01 | Moderate biofilm | Bordeaux | S− | icaA −/icaD − |
| S15 | 0.23 ± 0.01 | Moderate biofilm | Bordeaux | S− | icaA+/icaD + |
| S16 | 0.13 ± 0.03 | Moderate biofilm | Almost black | S− | icaA −/icaD − |
| S17 | 0.94 ± 0.04 | Moderate biofilm | Very Black | S+ | icaA+/icaD + |
| S18 | 0.24 ± 0.02 | Moderate biofilm | Bordeaux | S− | icaA −/icaD − |
| S19 | 0.54 ± 0.01 | Moderate biofilm | Bordeaux | S− | icaA+/icaD + |
| S20 | 0.26 ± 0.03 | Moderate biofilm | Bordeaux | S− | icaA+/icaD + |
| S21 | 0.45 ± 0.01 | Moderate biofilm | Bordeaux | S− | icaA+/icaD + |
| S22 | 0.67 ± 0.02 | Moderate biofilm | Bordeaux | S− | icaA+/icaD + |
| S23 | 0.46 ± 0.02 | Moderate biofilm | Bordeaux | S− | icaA+/icaD + |
| S24 | 0.44 ± 0.02 | Moderate biofilm | Bordeaux | S− | icaA+/icaD + |
| % of positivity | 8.33% | 83.33% |
| Strains | cna | clfA | fnbA | fnbB | % of the Presence of the Four Genes |
|---|---|---|---|---|---|
| S. aureus ATCC 43300 | + | + | + | + | 100% |
| S1 | + | + | + | + | 100% |
| S2 | − | − | − | − | 0% |
| S3 | + | + | − | + | 75% |
| S4 | + | − | − | + | 50% |
| S5 | + | − | − | + | 50% |
| S6 | + | − | − | − | 25% |
| S7 | − | − | − | − | 0% |
| S8 | + | + | + | + | 100% |
| S9 | + | + | + | + | 100% |
| S10 | − | − | + | − | 25% |
| S11 | − | − | − | − | 0% |
| S12 | − | − | − | − | 0% |
| S13 | + | + | + | + | 100% |
| S14 | − | − | − | − | 0% |
| S15 | + | − | − | − | 25% |
| S16 | − | − | − | − | 0% |
| S17 | + | + | − | − | 50% |
| S18 | + | + | − | − | 50% |
| S19 | + | − | − | − | 25% |
| S20 | + | + | + | + | 100% |
| S21 | + | + | − | − | 50% |
| S22 | + | + | + | + | 100% |
| S23 | + | + | − | − | 50% |
| S24 | + | + | + | − | 75% |
| % of positivity | 75% | 54.16% | 37.5% | 41.66% |
| Strains | mecA | norA | norB | blaZ | % of the Presence of the Four Genes |
|---|---|---|---|---|---|
| S. aureus ATCC | + | + | + | + | 100% |
| S1 | + | + | + | + | 100% |
| S2 | − | − | − | − | 0% |
| S3 | + | − | − | + | 50% |
| S4 | + | − | + | − | 50% |
| S5 | + | − | − | + | 50% |
| S6 | + | − | + | + | 75% |
| S7 | − | − | − | + | 25% |
| S8 | + | + | + | + | 100% |
| S9 | + | + | + | + | 100% |
| S10 | − | − | − | − | 0% |
| S11 | − | − | + | + | 50% |
| S12 | − | − | − | + | 25% |
| S13 | − | + | + | − | 50% |
| S14 | − | − | − | + | 25% |
| S15 | − | + | + | − | 50% |
| S16 | − | − | − | + | 25% |
| S17 | − | − | − | − | 0% |
| S18 | − | − | − | − | 0% |
| S19 | − | − | − | + | 25% |
| S20 | − | + | + | + | 75% |
| S21 | − | + | + | + | 75% |
| S22 | − | + | + | + | 75% |
| S23 | + | + | + | + | 100% |
| S24 | + | + | + | + | 100% |
| % of positivity | 41.66% | 45.83% | 58.33% | 75% |
Disclaimer/Publisher’s Note: The statements, opinions and data contained in all publications are solely those of the individual author(s) and contributor(s) and not of MDPI and/or the editor(s). MDPI and/or the editor(s) disclaim responsibility for any injury to people or property resulting from any ideas, methods, instructions or products referred to in the content. |
© 2023 by the authors. Licensee MDPI, Basel, Switzerland. This article is an open access article distributed under the terms and conditions of the Creative Commons Attribution (CC BY) license (https://creativecommons.org/licenses/by/4.0/).
Share and Cite
Alabbosh, K.F.; Zmantar, T.; Bazaid, A.S.; Snoussi, M.; Noumi, E. Antibiotics Resistance and Adhesive Properties of Clinical Staphylococcus aureus Isolated from Wound Infections. Microorganisms 2023, 11, 1353. https://doi.org/10.3390/microorganisms11051353
Alabbosh KF, Zmantar T, Bazaid AS, Snoussi M, Noumi E. Antibiotics Resistance and Adhesive Properties of Clinical Staphylococcus aureus Isolated from Wound Infections. Microorganisms. 2023; 11(5):1353. https://doi.org/10.3390/microorganisms11051353
Chicago/Turabian StyleAlabbosh, Khulood Fahad, Tarek Zmantar, Abdulrahman S. Bazaid, Mejdi Snoussi, and Emira Noumi. 2023. "Antibiotics Resistance and Adhesive Properties of Clinical Staphylococcus aureus Isolated from Wound Infections" Microorganisms 11, no. 5: 1353. https://doi.org/10.3390/microorganisms11051353
APA StyleAlabbosh, K. F., Zmantar, T., Bazaid, A. S., Snoussi, M., & Noumi, E. (2023). Antibiotics Resistance and Adhesive Properties of Clinical Staphylococcus aureus Isolated from Wound Infections. Microorganisms, 11(5), 1353. https://doi.org/10.3390/microorganisms11051353

